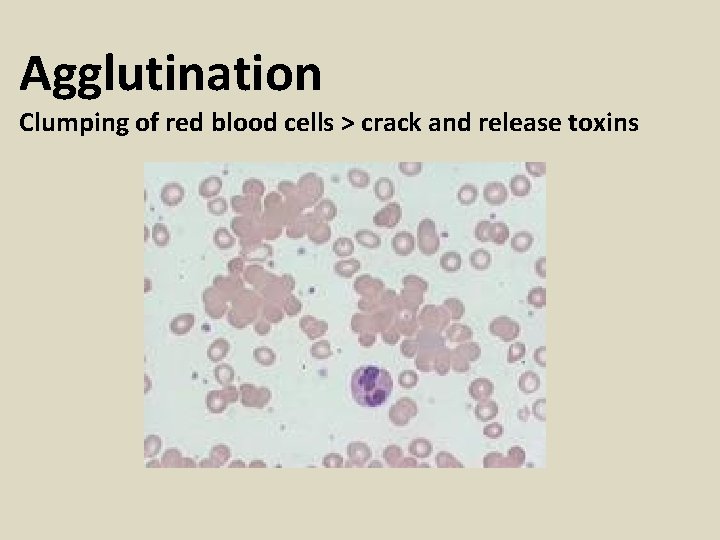
Agglutination Clumping of red blood cells > crack and release toxins

CELL MEMBRANE Structure Fits Function applied to the

CELL MEMBRANE

Structure Fits Function (applied to the cell membrane) The way the cell membrane is shaped and the parts it has allows it to do its job.

Phospholipid main molecule of the cell membrane

Phospholipid main molecule of the cell membrane “likes” water (hydrophilic) (is attracted to water molecules) doesn’t “like” water (hydrophobic) (repels water molecules) How would many of these arrange themselves to be the cell membrane (considering there is water inside the cell AND outside the cell)?

Does your model look like this?

Phospholipid Bilayer thin membrane made of two layers of lipid molecules

1 The cell membrane must be a good barrier between the watery environment inside the cell and the watery environment outside the cell.

What TWO qualities make the membrane a good barrier? 1. Form a film of bubble solution on your straw device. Bend and fold the straws. What quality of the soapy membrane are you observing? 2. Float a small rubber band on the bubble film. Then pop the film inside the circle. Now gently remove the rubber band. What happens?

TWO qualities the cell membrane has… 1 a. Flexible 1 b. Self sealing

Would you describe the soapy membrane as strong? The membrane needs to be strong in order to be a good barrier.

Cholesterol Molecules provide strength and prevent freezing

2 The cell membrane must let substances in and out

Set-up and observe. 1. Fill the bag with starch solution. 2. Tie off the end tightly. 3. Wash the outside of the bag. 4. Put the bag in a beaker of iodine.

What happened?

What can we infer about the cell membrane from this?

Which of these photos is most like the cell membrane?

Selective Permeability property that allows some substances to pass through more easily than others (based on size and charge)

2 The cell membrane must let substances in and out WHAT GOES IN? WHAT COMES OUT? How do larger substances get across?

Transport Protein Moves larger or charged molecules across the membrane

3 The cell membrane receives signals

Receptor Protein Receives signals from hormones or neurotransmitters They receive signals based on shape.

What are “signals” in the body? HORMONES chemical substances that act like messenger molecules throughout the body (brain, blood, etc. ) NEUROTRANSMITTERS chemical substance, that transmits nerve signals across a nerve cell. Are found in the brain and the nervous system. INSULIN – (pancreas cells have insulin DOPAMINE - is responsible for receptor proteins on them which then motivation, interest, and drive. It is allows sugar to enter the cells) associated with positive stress states such as being in love, exercising & TESTOSTERONE – (male reproductive listening to music. organs have receptor proteins on their cells which allows puberty to SEROTONIN is key to our feelings of occur along with growth and strength happiness and very important for our of muscles) emotions because it helps defend against both anxiety and depression. ESTROGEN – (female reproductive organs have receptor proteins on their cells which allows puberty to occur)

4 The cell membrane identifies the cell CARDIAC MUSCLE CELL

Marker Protein Act like name tags for a cell

Blood Type – ex of Marker Proteins Karl Landsteiner 1901 Result = safe blood transfusions
Agglutination Clumping of red blood cells > crack and release toxins

Blood Type What are the four main blood types? O+ OA+ AB+ BAB + AB - Caucasians African American Hispanic Asian 37% 8% 33% 7% 9% 2% 3% 1% 47% 4% 2% 18% 1% 4% 0. 3% 53% 4% 29% 2% 9% 1% 2% 0. 2% 39% 1% 27% 0. 5% 25% 0. 4% 7% 0. 1%

BLOOD GROUPS IN THE WORLD Blood type O: the Americas Most common blood type in populations around the world, including the USA and Western Europe. Among indigenous populations of Central and South America, the frequency of O blood type is extremely high, approaching 100%. It is also high among Australian aborigines. Blood Type A: Central and Eastern Europe Type A is common in Central and Eastern Europe. In countries such as Austria, Denmark, Norway, and Switzerland, about 45 -50% of the population have this blood type, whereas about 40% of Poles and Ukrainians do so. The highest frequencies are found in small, unrelated populations. For example, about 80% of the Blackfoot Indians of Montana have blood type A. Blood type B: Asia Blood type B is relatively common in Chinese and Indians, being present in up to 25% of the population. It is less common in European countries and Americans of European origin, being found in about 10% of these populations. Blood type AB is the least common It is the rarest of the blood groups. It is most common in Japan, regions of China, and in Koreans, being present in about 10% of these populations.

Antigen any substance to which the immune system can respond What do you notice about these antigens?

RBC Antigens- marker proteins on the RBC

Antibody Protein used by the immune system to identify and destroy foreign objects ANTIGENS AND ANTIBODIES FIT TOGETHER LIKE A LOCK AND KEY

RBC Antibodies- proteins in our blood plasma (NOT on the RBC)

Agglutination Why it happens…


Antigens and Antibodies in the Immune System

Discovery S. Singer and G. Nicolson in 1972 FLUID MOSAIC MODEL Define in 3 phrases: 1. 2. 3.

FLUID MOSAIC MODEL A model of the cell membrane that describes it as made of little parts that are flexible & constantly moving. 1. 2. 3.

FLUID MOSAIC MODEL Marker proteins Transport protein Marker protein Receptor protein


Watch this video of the cell membrane in action. http: //www. youtube. com/watch? v=Qqsf_UJcf. Bc
- Slides: 40